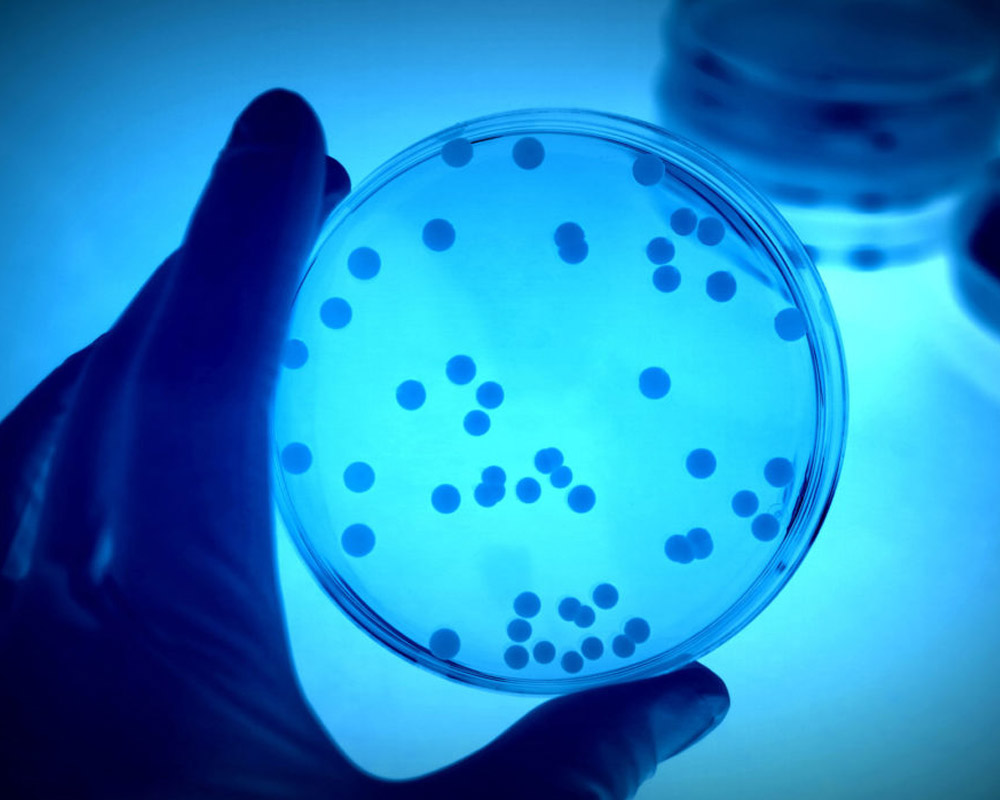
prevencion-de-la-legionelosis

SERVICIOS
OFRECEMOS SERVICIOS PERSONALIZADOS
PARA CADA CLIENTE
SERVICIOS
OFRECEMOS SERVICIOS PERSONALIZADOS PARA CADA CLIENTE
Servicios
En Vatten nos especializamos en ofrecer soluciones integrales para el tratamiento de aguas industriales. Nuestra experiencia y conocimientos nos permiten proporcionar servicios de alta calidad en la aplicación de productos químicos, diseño e instalación de equipos, y estudios personalizados para encontrar las soluciones más óptimas.
Nos dedicamos a mejorar la calidad del agua utilizada en procesos industriales, asegurando la eficiencia y seguridad de sus instalaciones. Además, cumplimos con las normativas vigentes para minimizar los riesgos asociados a la proliferación y diseminación de la Legionella, garantizando ambientes industriales seguros y saludables.
Tratamiento de aguas de circuitos industriales
El tratamiento de aguas en circuitos industriales es un proceso crucial para garantizar la eficiencia operativa, la longevidad del equipo y la conformidad con las normativas ambientales. Este proceso implica varias etapas y métodos diseñados para eliminar contaminantes, controlar la corrosión y prevenir la formación de incrustaciones y microorganismos.
· Torres de refrigeración.
· Calderas de vapor.
· Circuitos cerrados.
Prevención de la legionelosis
La legionelosis es una infección causada por bacterias del género Legionella, que pueden proliferar en sistemas de agua. La prevención de la legionelosis en entornos industriales y comerciales requiere un enfoque integral y riguroso en el mantenimiento y tratamiento de los sistemas de agua.
· Torres de refrigeración, condensadores evaporativos.
· Humidificadores.
· Circuitos ACS y AFCH.
· Depósitos contraincendios.
· Lavado de vehículos, riegos por aspersión.
· Resto de instalaciones descritas en la normativa vigente.
Fabricación y suministro de equipos
Garantizamos que nuestros clientes reciban soluciones integrales y eficaces para el tratamiento de aguas industriales, respaldadas por un servicio de instalación y mantenimiento de primera clase.
· Tratamiento del agua.
· Dosificación y control.
· Instalación y mantenimiento.
Asesoría para optimización de equipos
La optimización de los equipos de tratamiento del agua es fundamental para maximizar la eficiencia operativa, reducir costos y garantizar el cumplimiento de las normativas ambientales. Nuestra asesoría se enfoca en proporcionar soluciones personalizadas que aborden las necesidades específicas de cada cliente.
· Optimización de tratamientos.
· Búsqueda de soluciones para optimizar el uso del agua.